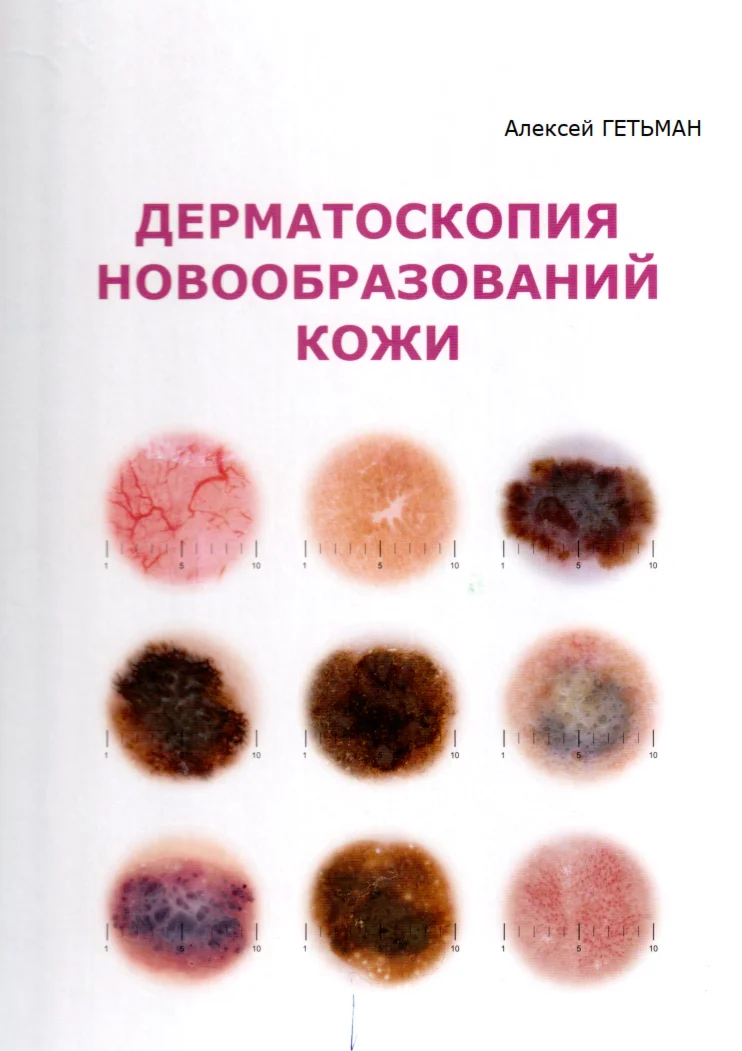
Дерматоскопия новообразований кожи. А.Д. Гетьман

USSR SHOP »
Магазин » Грибковые заболевания кожи
Купить Грибковые заболевания кожи
Всего продаж: 0
✅ Методы оплаты: 

















Описание товара:
Грибковые заболевания кожи (Руководство для врачей) Родионов А.Н. 2000г.
Во втором издании руководства приведены данные об этиологии, патогенезе, клинике, современных методах диагностики грибковых заболеваний кожи. Особое внимание уделено дифференциальной диагностике и профилактике поверхностных дерматомикозов. Рассмотрены современные средства и методы этиотропной и патогенетической терапии. Специальная глава посвящена особенностям течения, диагностики и терапии дерматомикозов у ВИЧ-инфицированных больных. Для дерматологов, инфекционистов, семейных врачей и студентов медицинских вузов.
Пароль для открытия документа: Surgerycom
Во втором издании руководства приведены данные об этиологии, патогенезе, клинике, современных методах диагностики грибковых заболеваний кожи. Особое внимание уделено дифференциальной диагностике и профилактике поверхностных дерматомикозов. Рассмотрены современные средства и методы этиотропной и патогенетической терапии. Специальная глава посвящена особенностям течения, диагностики и терапии дерматомикозов у ВИЧ-инфицированных больных. Для дерматологов, инфекционистов, семейных врачей и студентов медицинских вузов.
Пароль для открытия документа: Surgerycom
